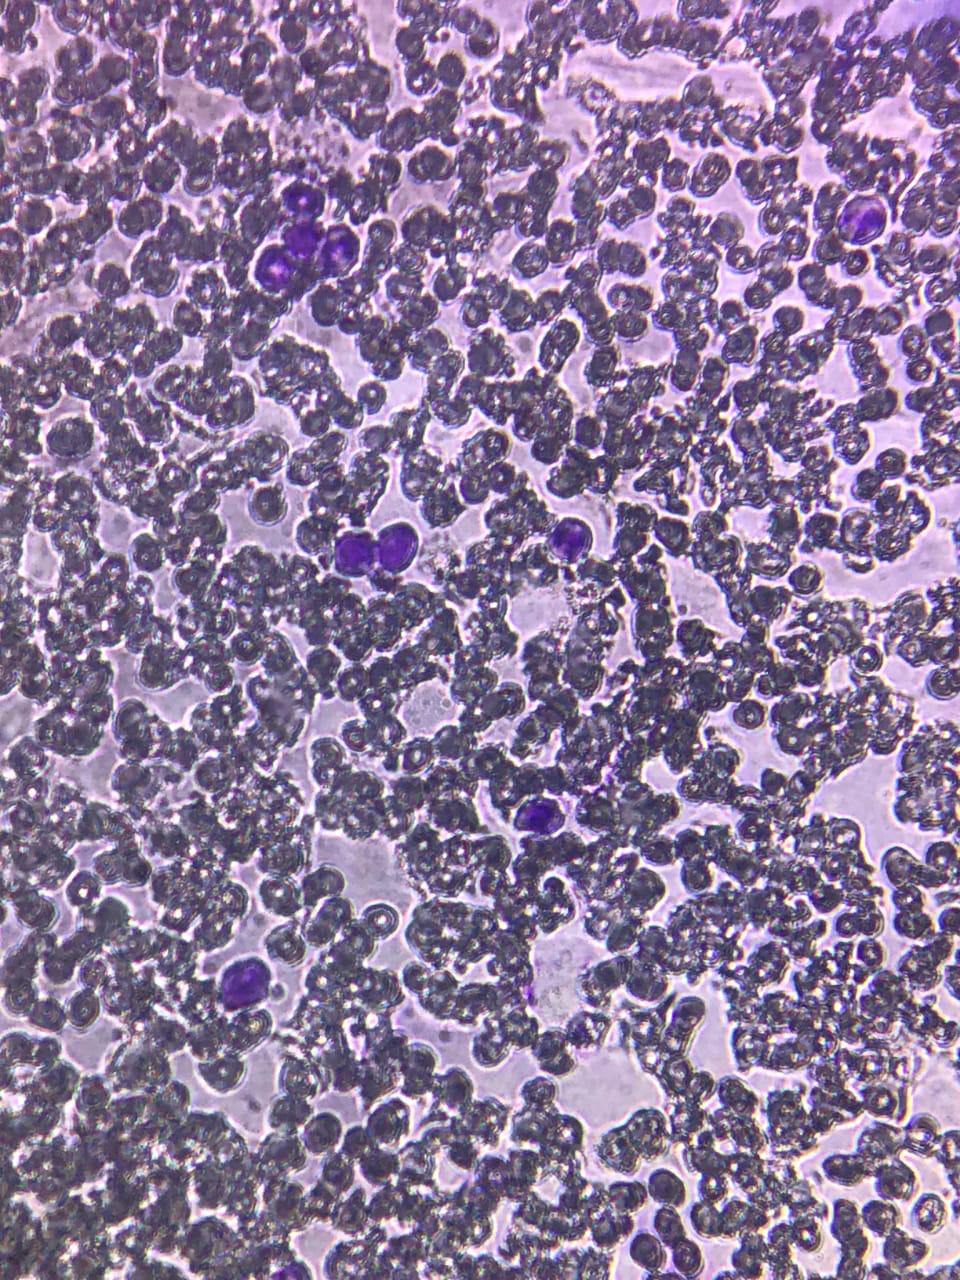
DLC slide under microscope showing different types of Leucocytes

SHRI SHIVAJI SCIENCE COLLEGE, AMRAVATI
DBT STAR COLLEGE PROJECT ACTIVITY
ACTIVITY REPORT

To determine the relative proportions (differential count) of white blood corpuscles in our own blood sample.
Activity Dates: 24/09/2025
Type of Activity: Other
Organizing Department: Department of Zoology
Program Coordinators: Dr. A. R. Rajoria
Head of the Department: Dr. J. D. Dhote
External Collaborator (if any): -
Objectives:
- 1. To determine the percentage distribution of different types of white blood cells (leucocytes) in a blood smear
- 2. To identify and differentiate various types of leucocytes
- 3. To calculate the relative percentage (%) of each type of white blood cell.
- 4. To assess the morphology (shape, size, staining characteristics) of leucocytes
- 5. To help in the diagnosis and monitoring of infections, allergies, inflammatory conditions, and blood disorders.
No of Beneficieries: 17
Classes Involved: B. Sc. IIIrd Year Students
Venue of the Activity: Department of Zoology, Shri Shivaji Science College, Amravati
Activity Report:
Department of Zoology has conducted an experiment on Differential Leucocytes Count (DLC) for the students of B. Sc. III year and for this practical, a protocol is designed. Before performing the practical, students were given the knowledge about the different types of Leucocytes present in human blood, their identifying features, their role in immunity etc.
For this practical, Leishman’s Stain is prepared which is is a neutral stain for blood smears which was devised by the British surgeon W. B. Leishman (1865–1926). It consists of a mixture of eosin (an acidic stain), and Methylene blue (a basic stain) in Methyl alcohol and is usually diluted and buffered during the staining procedure. It stains the different components of blood in a range of shades between red and blue.
Normal differential Leukocyte count
Neutrophils: 2.0-7.0X109/ L (40-80%)
Lymphocytes: 1.0- 3.0X109/ L (20-40%)
Monocytes: 0.2- 1.0 X109/ L (2-10%)
Eosinophils: 0.02-0.5 X109/ L (1-6%)
Basophils: 0.02-0.1 X109/ L (1-2%)
After demonstration, students carefully, sterilize their finger with alcohol and performed the practical by provided materials like sterilized needle, clean slide, Leishman’s stain and microscope according to the following steps:
1. Prick the finger with a sterilized needle and take a drop on the end of a clean slide, place the slide on a smooth surface holding it steady with the left hand.
2. Hold a second slide or drawing slide at 450 just in front of the drop of the blood, draw this slide in such a way that the blood spreads along its edge.
3. Push the second or drawing slide forward 450 on the first slide without exerting any pressure, a film of blood will be made on the first slide.
4. Dry the blood film in air, but do not heat it. Stain the blood film with Leishman's stain or Wright's stain. Wait and after one minute carefully add distilled water to the stain, the water should be twice the volume of the stain used.
5. Mix the water and stain well by sucking the mixture in and out of a pipette. After some time, a greenish metallic scum forms on the surface of the mixture. Allow the diluted stain to act from 7 to 10 minutes.
6. Drain off the stain and wash film for 10 seconds with distilled water. The film should be rose pink in colour, if it is too purple, then wash again with distilled water. Dry the slide and examine it under the microscope for white blood corpuscles.
After following all the steps, students, first examined the stained film under low power of microscope to get an idea of leucocytes and then examined it under high power of the microscope.
In a longitudinal strip of the film, students counted the various kinds of white blood corpuscles from top to the bottom. They counted 100 white corpuscles and noted it on a paper each type of white blood corpuscles encountered and calculated the percentage.
Detailed morphological and anatomical structures were observed by the students under a compound microscope and the outlined aims, objectives as well as outcomes were achieved.
This activity was successfully organized and conducted under the guidance of Dr. J. D. Dhote, Prof. & Head, Department of Zoology and Dr. G. A. Wagh, Prof. & Departmental DBT Coordinator, Dr. A. R. Rajoria, Asstt. Prof. & Activity Incharge, Dr. G. D. Hande, Dr. S. V. Gawande, Dr. S. J. Kawade, Dr. P. M. Ramteke, Asstt. Prof. and non-teaching staff of department of Zoology.
Outcomes:
- 1. Students provide the percentage (%) of each type of leucocyte in the sample
- 2. Students will identify and differentiate various types of leucocytes
- 3. Students will calculate the relative percentage (%) of each type of white blood cell.
- 4. Students will assess the morphology (shape, size, staining characteristics) of leucocytes
- 5. Students will help in the diagnosis and monitoring of infections, allergies, inflammatory conditions, and blood disorders.
Photos:
 Students involvement in DLC practical |  Blood Smear prepared by students for performing the DLC Practical |
 Slide preparation by the students | DLC slide under microscope showing different types of Leucocytes |
 Different types of Leucocyte seen in the side under Microscope |  Dr. A. R. Rajoria, explaining the different Leucocytes present in the prepared slide |
Attendance Sheet:
 |